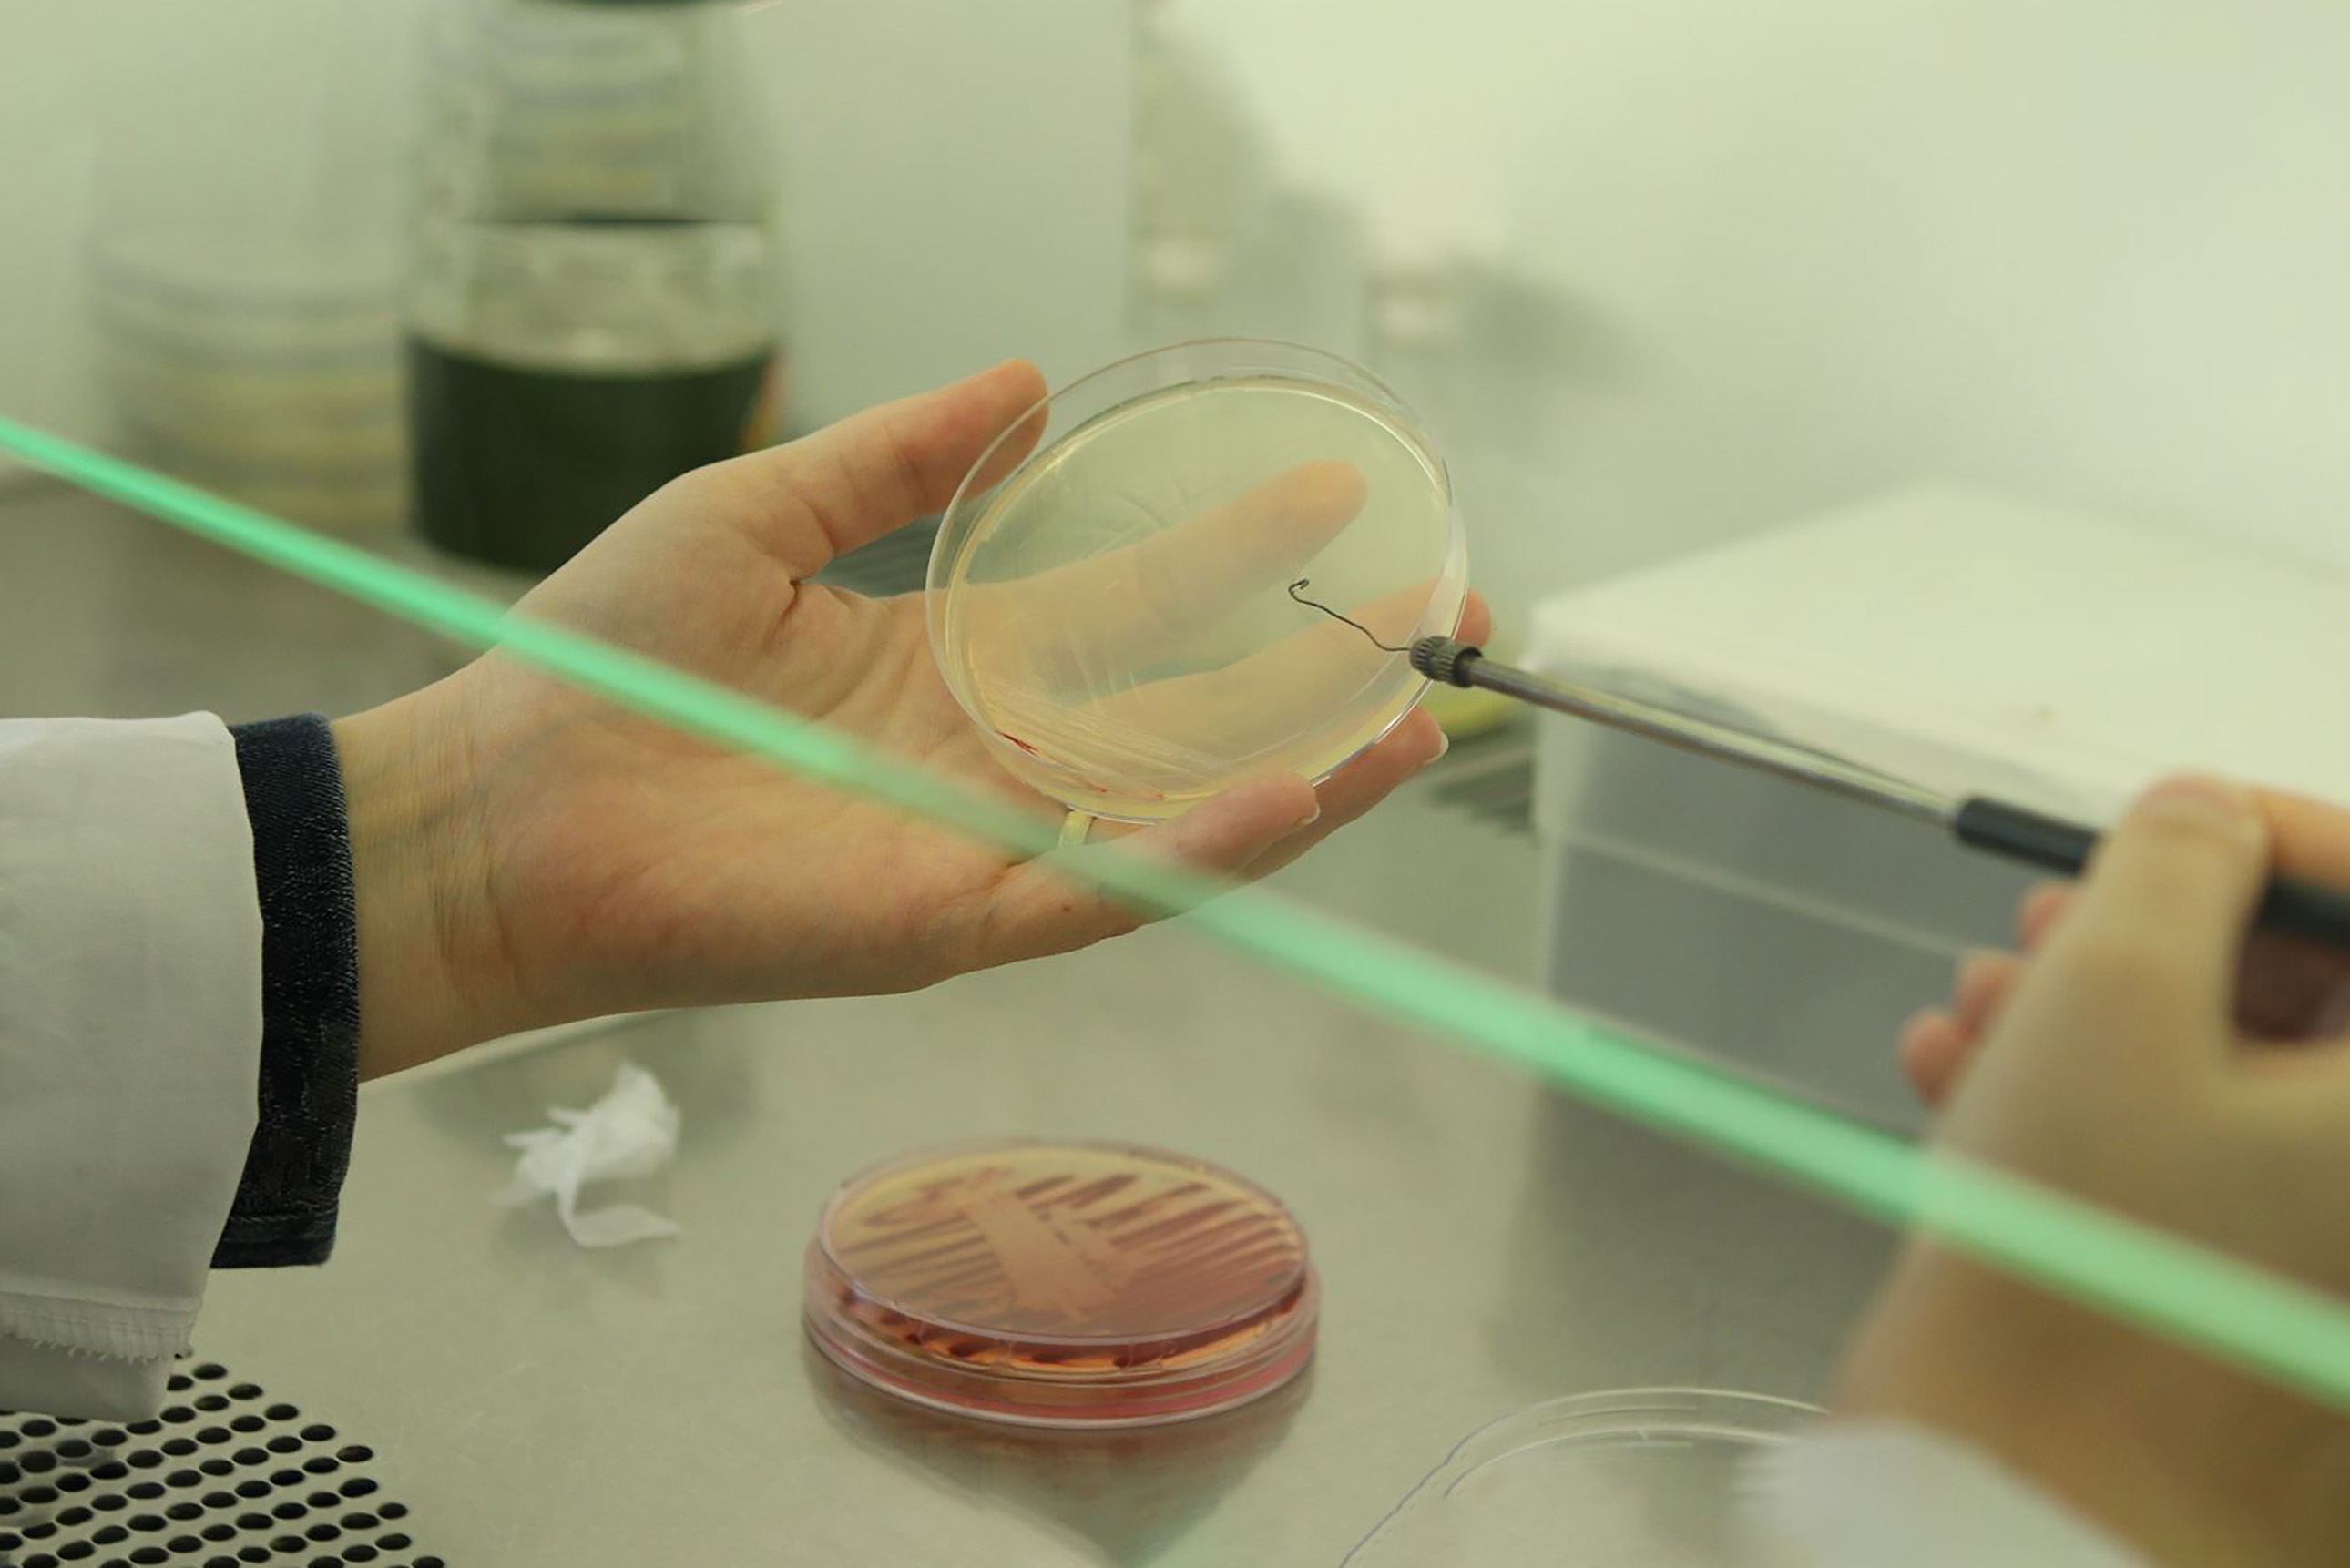

Uluslararası Yükseköğretim Derecelendirme kuruluşu AD Scientific Index’in 219 ülkeden yaklaşık 1,4 milyon bilim insanı ve 22 bin 635 üniversiteyi değerlendirdiği ‘Dünya Bilim İnsanları Sıralaması’na Karamanoğlu Mehmetbey Üniversitesinden (KMÜ) 107 akademisyen girmeyi başardı.En çok atıf alan ve en yüksek h index’ine sahip akademisyenleri gösteren listede KMÜ’lü bilim insanlarından Dr. Öğr. Üyesi Sinan Sağır, Doç. Dr. Osman Ağar, Prof. Dr. Savaş Sönmezoğlu, Prof. Dr. Faruk Özel, Prof. Dr. İbrahim Yılmaz, Doç. Dr. Kadir Sabancı, Prof. Dr. Uğur Köklü, Prof. Dr. Nejla Canbulat Şahiner, Prof. Dr. Gökhan Sadi ve Dr. Öğr. Üyesi Yasin Uzun ilk 10’a girdi. “Tüm akademisyenlerimizi tebrik ediyorum”2024 Dünya Bilim İnsanları Sıralamasının açıklanmasının ardından değerlendirmelerde bulunan Rektör Prof. Dr. Mehmet Gavgalı ”Üniversitemiz akademik başarıları ile adından söz ettirmeye devam ediyor. Üretkenlikleri ve başarıları ile göğsümüzü kabartan tüm akademisyenlerimizi tebrik ediyorum.” dedi.
Eğitim
Yayınlanma: 06 Aralık 2023 - 17:32
KMÜ'nün 107 akademisyeni dünya sıralamasında yer aldı
Uluslararası sıralama kuruluşu AD Scientific Index 2024 Dünya Bilim İnsanları Sıralaması (World Scientist and University Rankings 2024) sonuçları açıklandı.
Eğitim
06 Aralık 2023 - 17:32
EDİTÖR
İlginizi Çekebilir